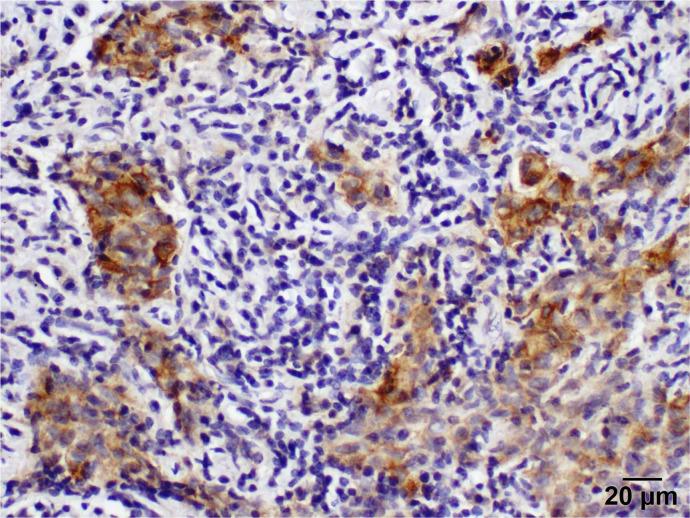

- 突变型非鳞状非小细胞肺癌(NSCLC)的分子谱分析是否有助于治疗策略的制定?
Does Molecular Profiling of -Mutant Non-Squamous Non-Small Cell Lung Cancer (NSCLC) Help in Treatment Strategy Planning?
机构信息
Inova Schar Cancer Institute, Department of Medicine, University of Virginia, Fairfax, VA 22031, USA.
Department of Pathology, Vanderbilt University Medical Center, Nashville, TN 37232, USA.
出版信息
Curr Oncol. 2022 Jul 7;29(7):4779-4790. doi: 10.3390/curroncol29070379.
Background: Several studies suggest that patients with KRAS-mutant NSCLC fail to benefit from standard systemic therapies and do not respond to EGFR inhibitors. Most recently, KRAS 12c data suggest specific treatment for improving ORR and OS. There is a clear need for therapies specifically developed for these patients. Moreover, data that might be suggestive of a response to specific therapies, such as BRCA1, are needed, and two mutations that were studied in other malignancies show more response to PARP inhibitors. Molecular profiling has the potential to identify other potential targets that may provide better treatment and novel targeted therapy for KRAS-mutated NSCLC. Methods: We purified RNA from archived tissues of patients with stage I and II NSCLC with wild-type (wt) and mutant (mt) KRAS tumors; paired normal tissue adjacent to the tumor from 20 and 17 patients, respectively, and assessed, using real-time reverse transcriptase−polymerase chain reaction (RT-PCR), the expression of four genes involved in DNA synthesis and repair, including thymidylate synthase (TS), BRCA1, ECCR1, RAP80, and the proto-oncogene SRC. Additionally, we assessed the expression of PD-L1 in mt KRAS tumors with immunohistochemistry using an antibody against PD-L1. Results: Our results show that in mtKRAS tumors, the level of expression of ERCC1, TS, and SRC was significantly increased in comparison to paired normal lung tissue (p ≤ 0.04). The expression of BRCA1 and RAP80 was similar in both mt KRAS tumors and paired normal tissue. Furthermore, the expression of BRCA1, TS, and SRC was significantly increased in wt KRAS tumors relative to their expression in the normal lung tissue (p < 0.044). The expression of ERCC1 and RAP80 was similar in wt KRAS tumors and paired normal tissue. Interestingly, SRC expression in mtKRAS tumors was decreased in comparison to wt KRAS tumors. Notably, there was an expression of PD-L1 in the tumor and stromal cells in a few (5 out of 20) mtKRAS tumors. Our results suggest that a greater ERCC1 expression in mt KRAS tumors might increase platinum resistance in this group of patients, whereas the greater expression of BRCA1 in wt KRAS tumor might be suggestive of the sensitivity of taxanes. Our data also suggest that the combination of an SRC inhibitor with a TS inhibitor, such as pemetrexed, might improve the outcome of patients with NSCLC and in particular, patients with wt KRAS tumors. PD-L1 expression in tumors, and especially stromal cells, suggests a better outcome. Conclusion: mt KRAS NSCLC patients might benefit from a treatment strategy that targets KRAS in combination with therapeutic agents based on pharmacogenomic markers, such as SRC and BRCA1. mtKRAS tumors are likely to be platinum-, taxane-, and pemetrexed-resistant, as well as having a low level of PD-L1 expression; thus, they are less likely to receive single-agent immunotherapy, such as pembrolizumab, as the first-line therapy. wt KRAS tumors with BRCA1 positivity tend to be sensitive to taxane therapy and, potentially, platinum. Our results suggest the need to develop targeted therapies for KRAS-mutant NSCLC or combine the targeting of oncogenic KRAS in addition to other therapeutic agents specific to the molecular profile of the tumor.
背景
多项研究表明,KRAS 突变型非小细胞肺癌(NSCLC)患者无法从标准的系统治疗中获益,也对 EGFR 抑制剂无反应。最近,KRAS 12c 数据提示了针对改善缓解率(ORR)和总生存期(OS)的特定治疗方法。因此,非常有必要开发专门针对这些患者的疗法。此外,需要针对特定疗法(如 BRCA1)可能有反应的相关数据,并且在其他恶性肿瘤中研究的两种突变对 PARP 抑制剂的反应更为明显。分子谱分析具有识别其他潜在靶点的潜力,这些潜在靶点可能为 KRAS 突变型 NSCLC 患者提供更好的治疗和新的靶向治疗。
方法
我们从具有野生型(wt)和突变型(mt)KRAS 肿瘤的 I 期和 II 期 NSCLC 患者的存档组织中提取 RNA;分别从 20 名和 17 名患者的肿瘤相邻正常组织中提取 RNA,并使用实时逆转录聚合酶链反应(RT-PCR)评估参与 DNA 合成和修复的四个基因的表达,包括胸苷酸合成酶(TS)、BRCA1、ECCR1、RAP80 和原癌基因 SRC。此外,我们使用针对 PD-L1 的抗体通过免疫组织化学法评估 mt KRAS 肿瘤中的 PD-L1 表达。
结果
我们的结果表明,与配对的正常肺组织相比,mtKRAS 肿瘤中 ERCC1、TS 和 SRC 的表达水平显著增加(p≤0.04)。mt KRAS 肿瘤和配对正常组织中 BRCA1 和 RAP80 的表达相似。此外,与正常肺组织相比,wt KRAS 肿瘤中 BRCA1、TS 和 SRC 的表达显著增加(p<0.044)。wt KRAS 肿瘤和配对正常组织中 ERCC1 和 RAP80 的表达相似。有趣的是,mtKRAS 肿瘤中 SRC 的表达与 wt KRAS 肿瘤相比有所降低。值得注意的是,在 5 个(20 个中的 5 个)mtKRAS 肿瘤中,肿瘤和基质细胞中存在 PD-L1 的表达。我们的结果表明,mt KRAS 肿瘤中更高的 ERCC1 表达可能会增加这组患者对铂类药物的耐药性,而 wt KRAS 肿瘤中更高的 BRCA1 表达可能提示对紫杉烷类药物的敏感性。我们的数据还表明,SRC 抑制剂与培美曲塞等 TS 抑制剂的联合应用可能会改善 NSCLC 患者的预后,尤其是 wt KRAS 肿瘤患者的预后。肿瘤,特别是基质细胞中的 PD-L1 表达提示预后更好。
结论
mt KRAS NSCLC 患者可能受益于一种治疗策略,即联合靶向 KRAS 与基于药物基因组学标志物的治疗药物,如 SRC 和 BRCA1。mtKRAS 肿瘤可能对铂类药物、紫杉烷类药物和培美曲塞耐药,并且 PD-L1 表达水平较低;因此,它们不太可能接受派姆单抗等单药免疫治疗作为一线治疗。具有 BRCA1 阳性的 wt KRAS 肿瘤倾向于对紫杉烷类药物治疗敏感,并且可能对铂类药物敏感。我们的结果表明,有必要针对 KRAS 突变型 NSCLC 开发靶向疗法,或者除了针对肿瘤分子谱的其他治疗药物外,还需要联合靶向致癌 KRAS。